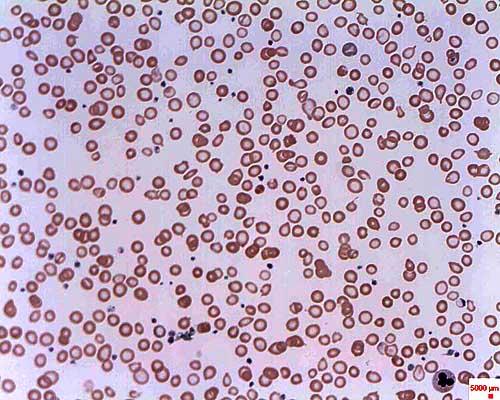

¿Qué es la eritropoyesis?
La eritropoyesis es el proceso mediante el cual se forman los glóbulos rojos o eritrocitos. Estas células sanguíneas, en los seres humanos, tienen un promedio de vida de 4 meses y no pueden reproducirse ellas mismas. Debido a ello deben crearse nuevos eritrocitos para reemplazar a los que mueren o son perdidos en hemorragias.
En hombres, el número de eritrocitos es de aproximadamente 54 millones por mililitro, y en mujeres es un poco menor (48 millones). Diariamente se pierden cerca de 10 millones de eritrocitos, por lo que debe reponerse una cantidad similar.
Los eritrocitos se forman a partir de unos eritroblastos nucleados presentes en la médula ósea roja de los mamíferos, mientras que en otros vertebrados se producen principalmente en los riñones y en el bazo.
Cuando llegan al final de sus días, se fragmentan. Luego, unas células denominadas macrófagos las engloban. Estos macrófagos están presentes en el hígado, la médula ósea roja y en el bazo.
Cuando los glóbulos rojos se destruyen, el hierro se recicla para ser nuevamente empleado, mientras que el resto de la hemoglobina es transformada en un pigmento biliar denominado bilirrubina.
La eritropoyetina es una hormona que estimula la eritropoyesis, pero el proceso está regulado por distintos factores, como la temperatura, la presión de oxígeno, entre otros.
Etapas y sus características
En organismos adultos, la eritropoyesis ocurre en lugares especializados de la médula ósea roja, denominados islas eritroblásticas. Para la formación de los eritrocitos deben ocurrir varios procesos, que van desde la proliferación celular hasta la maduración de los glóbulos rojos, pasando por varias etapas de diferenciación celular.
A medida que las células se dividen mitóticamente, van disminuyendo su tamaño y el de su núcleo, así como la condensación de la cromatina y la hemoglobinización. Adicionalmente, se van alejando de la zona de origen.
En las etapas finales pierden el núcleo y demás orgánulos y entran en circulación, migrando a través de poros citoplasmáticos de células endoteliales.
Algunos autores dividen todo el proceso de eritropoyesis en dos fases, proliferación y diferenciación celular, y otros dividen el proceso con base en características específicas de la célula en cada etapa, al ser observadas con tinción de Wright. Con base en esta última, las etapas de la eritropoyesis son:
1. Unidades formadoras de colonias en estallido
Son las primeras células sensibles a la eritropoyetina, se llaman progenitores mieloides, o también BFU-E, por sus siglas en inglés. Se caracterizan por expresar antígenos de superficie como el CD34, así como por la presencia de receptores de eritropoyetina en pocas cantidades.
2. Células formadoras de colonias eritroides
Abreviadas en inglés como CFU-E, son capaces de producir pequeñas colonias de eritroblastos. Otra característica de estas células es que las cantidades de receptores de eritropoyetina son mucho más elevadas que en las unidades formadoras de colonias en estallido.
3. Proeritroblastos
Considerados como el primer estado madurativo de los eritrocitos. Se caracterizan por su gran tamaño (14 a 19 µm según algunos autores, hasta 25 µm según otros). El núcleo es grande, redondeado, con cromatina dispuesta en forma de filamentos y 2 o 3 nucléolos.
En esta etapa se inicia la captación del hierro plasmático. Tienen una vida media de 20 horas, para dar paso por mitosis a la siguiente etapa.
4. Eritroblastos basófilos
También llamados normoblastos, son de menor tamaño que sus precursores. Estas células se tiñen de azul con tinción vital, es decir, son basófilas. El núcleo está condensado, los nucléolos han desaparecido y poseen una gran cantidad de ribosomas. En esta etapa comienza la síntesis de hemoglobina.
Al inicio son conocidos como eritroblastos basófilos tipo I y tras una división mitótica se transforman en tipo II, los cuales siguen siendo basófilos y presentan mayor síntesis de hemoglobina. La duración aproximada de ambas células, en conjunto, es similar a la de los proeritroblastos.
5. Eritroblastos policromatófilos
Se forman por división mitótica de los eritroblastos basófilos tipo II y son las últimas células con capacidad de dividirse por mitosis. Su tamaño oscila entre 8 y 12 µm, y presentan un núcleo redondeado y condensado.
El citoplasma de estas células se tiñe de gris plomo con la coloración de Wright. Presenta una concentración elevada de hemoglobina y la cantidad de ribosomas sigue siendo elevada.
6. Eritroblastos ortocromáticos
La coloración de estas células es rosada o roja debido a la cantidad de hemoglobina que poseen. Su tamaño es ligeramente menor que el de sus precursoras (7 a 10 µm) y presenta un núcleo pequeño, que será expulsado por exocitosis al madurar las células.
7. Reticulocitos
Se forman por diferenciación de los eritroblastos ortocromáticos, pierden los orgánulos y llenan su citoplasma de hemoglobina. Permanecen en la médula ósea roja de dos a tres días hasta migrar a la sangre, donde culminarán su maduración.
8. Eritrocitos
Son los elementos formes maduros, producto final de la eritropoyesis y que se forman por maduración de los reticulocitos. Poseen forma bicóncava debido a la ausencia de núcleo y a la interacción entre el citoesqueleto del eritrocito y dos proteínas denominadas espectrina y actina. En otros vertebrados son redondeadas y conservan el núcleo.
Son las células sanguíneas más abundantes, y se forman a partir de los reticulocitos.

Regulación de la eritropoyesis
Si bien la eritropoyetina estimula la formación de glóbulos rojos para mejorar la capacidad de transporte de oxígeno de la sangre, existen varios mecanismos fundamentales para regular esta formación, entre ellos:
Presión de oxígeno
La concentración de oxígeno en la sangre regula la eritropoyesis. Cuando esta concentración es muy baja en el flujo sanguíneo que llega el riñón, se estimula la producción de glóbulos rojos.
Esta baja concentración de O2 tisular puede ocurrir por hipoxemia, anemia, isquemia renal o cuando la afinidad de la hemoglobina por este gas es mayor a lo normal.
Antes se pensaba que había relación entre la hipoxia tisular y la eritropoyesis, pero esta hipoxia no estimula directamente a la médula ósea para que produzca glóbulos rojos. Al contrario, induce al riñón a la producción de eritropoyetina.
La producción de eritropoyetina debido a hipoxia tisular está regulada genéticamente y los receptores que detectan tal hipoxia se encuentran en el riñón. También se aumenta la producción de eritropoyetina debido a una baja en la presión parcial del oxígeno tisular tras una hemorragia.
Las células que producen la eritropoyetina se encuentran en el riñón y en el hígado. El incremento en la producción de esta hormona durante la anemia se debe a un incremento en el número de células que la producen.
Testosterona
La testosterona regula indirectamente la eritropoyesis, al regular los niveles de hierro en la sangre. Esta hormona actúa directamente sobre la acción de una proteína citoplasmática denominada BMP-Smad (proteína morfogenética de hueso-Smad, por sus siglas en inglés) en los hepatocitos.
Debido a la acción de la testosterona se suprime la transcripción de hepcidina. Esta hepcidina impide el paso del hierro desde las células hacia el plasma a partir de los macrófagos que reciclan el hierro, conduciendo a la disminución drástica del hierro sanguíneo.
Al ocurrir la hipoferremia habrá una inhibición de eritropoyetina, pues no habrá hierro para la producción de eritrocitos.
Temperatura
La temperatura ha mostrado tener un efecto sobre la eritripoyesis. Exposiciones a temperaturas muy bajas ocasionan la necesidad de producir calor en los tejidos.
Para ello se requiere incrementar la cantidad de eritrocitos con el fin de suministrar oxígeno a los tejidos periféricos. Sin embargo, no está completamente aclarado cómo ocurre este tipo de regulación.
Regulación paracrina
Aparentemente, existe una producción de eritropoyetina por parte de las neuronas del sistema nervioso central, para autoprotegerse de daños isquémicos y apoptosis. Sin embargo, los científicos no lo han podido comprobar aún.
Agentes estimulantes de la eritropoyesis
Los agentes estimulantes de la eritropoyesis (ESA, por sus siglas en inglés) son agentes que estimulan la producción de eritrocitos. La eritropoyetina es la hormona naturalmente encargada de este proceso, pero también existen unos productos sintéticos con similares propiedades.
La eritropoyetina es una hormona sintetizada principalmente en el riñón. Durante las primeras etapas del desarrollo, el hígado también participa en la producción activa de eritropoyetina. Sin embargo, a medida que avanza el desarrollo, este último órgano tiene una participación menos importante en el proceso.
El eritrocito empieza a dispersar receptores para la eritropoyetina en la superficie de membrana. La eritropoyetina activa una serie de cascadas de transducción de señales intercelulares que inicialmente producen la síntesis de hemoglobina y hace que los reticulocitos actúen de manera más rápida y sean liberados a la circulación.
ESA artificiales
Los ESA artificiales son clasificados en generaciones (primera a tercera), dependiendo de la fecha en las cuales fueron creados y comercializados. Se asemejan estructural y funcionalmente a la eritropoyetina.
Los ESA de primera generación se conocen como epoetina alfa, beta y delta. Las dos primeras son producidas por recombinación a partir de células animales y tienen una vida media de cerca de 8 horas en el organismo. La epoetina delta, por su parte, es sintetizada a partir de células humanas.
La darbepoetina alfa es un ESA de segunda generación, producido a partir de células de hámster chino mediante la tecnología denominada ADN recombinante. Tiene una vida media más de tres veces superiores a los ESA de primera generación. Al igual que ocurre con las epoetinas, algunos deportistas de alto rendimento han empleado la darbepoetina como medio de dopaje.
Activador continuo del receptor de la eritropoetina, o CERA por sus siglas en inglés, es el nombre genérico de los ESA de tercera generación. No intentan simular la estructura y función de la eritropoyetina, sino que actúan estimulando al receptor de esta, aumentando así sus efectos.
Su vida media es de varias semanas en lugar de horas, como los fármacos anteriores. Utilizada comercialmente desde 2008, sin embargo, su uso ilícito en actividades deportivas aparentemente data de dos o tres años antes de su comercialización lícita.
Eritropoyesis ineficaz
La eritropoyesis inefectiva o ineficaz ocurre cuando los glóbulos rojos formados son defectuosos y generalmente son destruidos antes de abandonar la médula ósea o poco tiempo después de esto.
La eritropoyesis ineficaz puede deberse a defectos en la síntesis de ácidos nucleicos, del grupo hemo, o de las globinas. Estos defectos ocasionan distintos tipos de anemia.
Defectos en la síntesis de ácidos nucleicos
En este caso hay deficiencia de ácido fólico y cobalamina, se inhibe la síntesis de ADN en el núcleo de las células promotoras de los eritrocitos, por lo que estas son incapaces de dividirse mitóticamente. El citoplasma, por su parte, sí incrementa su volumen (macrocitosis), originándose una célula de gran tamaño denominada megaloblásto.
En estos casos se originan una serie de anemias denominadas anemias megaloblásticas, de las cuales la más común es la anemia perniciosa. En esta enfermedad no hay absorción de vitamina B12 en el intestino delgado.
Otras causas de anemia megaloblástica incluyen enfermedades digestivas, malabsorción, deficiencia de ácido fólico y debido a ciertos medicamentos.
Entre los síntomas de este tipo de anemia se encuentran palidez anormal, irritabilidad, inapetencia, diarrea, dificultad para caminar o debilidad muscular. Dependiendo de la causa, puede ser tratada con suplementos vitamínicos o de ácido fólico.
Defectos en la síntesis del grupo hemo
La eritropoyesis ineficaz por deficiencia en la síntesis de hierro puede ocasionar dos tipos de anemia: la anemia microcítica por déficit de hierro y la anemia sideroblástica.
Se conoce como anemia microcítica a un grupo de anemias caracterizadas por eritrocitos de tamaño reducido y de coloración pálida, pueden tener distintos orígenes, incluyendo la talasemia y la eritropoyesis ineficaz.
En la anemia sideroblástica los niveles de hierro y de hemosiderina son muy elevados. La hemosiderina es un pigmento amarillo que deriva de la hemoglobina y aparece cuando los niveles del metal son superiores a lo normal. Este tipo de anemia ocasiona la muerte de los basófilos en la médula ósea roja y no hay síntesis de hemoglobina.
Se le llama anemia sideroblástica debido a que los eritrocitos se desarrollan anormalmente por acumulación de hierro en forma de gránulos, recibiendo el nombre de sideroblastos. La anemia sideroblástica puede ser congénita o puede ser secundaria y tener distintas causas.
Defectos en la síntesis de globinas
En este caso, se presentan la anemia drepanocítica y la talasemia beta. La anemia drepanocítica es también conocida como anemia falciforme. Se produce por una mutación genética que lleva a la sustitución del ácido glutámico por la valina durante la síntesis de la globina beta.
Debido a tal sustitución, disminuye la afinidad de la hemoglobina por el oxígeno y hay atrofia del eritrocito, adquiriendo forma de hoz en lugar de la forma normal de disco bicóncavo. El paciente con anemia drepanocítica es susceptible de padecer microinfartos y hemólisis.
La talasemia es una enfermedad producto de una codificación genética inadecuada de las α- y β- globinas que conlleva a una muerte temprana del eritrocito. Existe cerca de un centenar de mutaciones distintas que pueden provocar talasemia con distintos grados de severidad.
Referencias
- Erithropoiesis.Recuperado de en.wikipedia.org.
- Fisiología de la eritropoyesis. Recuperado de cerebromedico.com.
- Anemia. Recuperado de en.wikipedia.org.
- Erithropoiesis stimulating agent. Recuperado de en.wikipedia.org.
- Ineffective erithropoiesis. Recuperado de en.wikipedia.org.